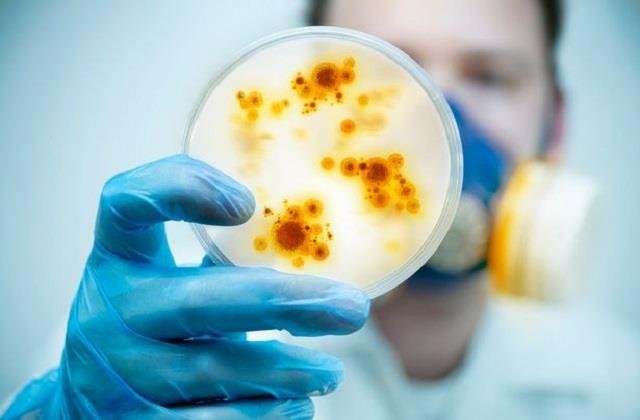

आ गया कोरोना से भी खतरनाक वायरस! Lungs पर कर रहा सीधा अटैक, एंटीबायोटिक का भी इस पर नहीं कोई असर
डेस्क: मलेशिया में एक घातक सुपरबग फैलने की रिपोर्ट ने चिंता बढ़ा दी है। इस “डेडली सुपरबग”के मामलों में तेजी से बढ़ोतरी देखी जा रही है, यह लोगों के खून और लंग्स में इंफेक्शन फैला रहा है। चिंता की बात तो यह है कि इसका इंफेक्शन होने पर एंटीबायोटिक दवाएं भी असर नहीं कर रही हैं। यह सिर्फ मलेशिया ही नहीं बाकि देशों में फैल चुका है, जिससे अलर्ट रहने की जरूरत है।
सुपरबग क्या होता है
सुपरबग वो बैक्टीरिया होते हैं जो आमतौर पर इस्तेमाल होने वाली एंटीबायोटिक दवाओं पर असर नहीं होने देते। यानी जब व्यक्ति को संक्रमण होता है और उसे दवा दी जाती है, तब ये बैक्टीरिया मरते नहीं, बल्कि और मजबूत हो जाते हैं। मलेशिया में जो सुपरबग सामने आया है, उसमें सबसे ज्यादा चिंता Carbapenem-resistant Acinetobacter baumannii (CRAB) को लेकर है। यह एक प्रकार का बैक्टीरिया है जो सामान्यतः अस्पतालों में फैलता है। यह बैक्टीरिया फेफड़ों में संक्रमण, खून में संक्रमण, घाव में इंफेक्शन और मूत्र संक्रमण का कारण बन सकता है। यह खासकर ICU, वेंटिलेटर पर मौजूद मरीजों और कमजोर इम्युनिटी वाले लोगों के लिए खतरनाक होता है।
क्यों है यह खतरनाक?
यह बैक्टीरिया Carbapenem जैसी आखिरी विकल्प की मानी जाने वाली एंटीबायोटिक दवा पर भी असर नहीं होने देता। इससे संक्रमित मरीजों का इलाज करना बेहद मुश्किल हो जाता है। मलेशिया के अस्पतालों में इस बैक्टीरिया के कारण मृत्यु दर 30% से ज्यादा देखी गई है। यह बैक्टीरिया संक्रमित सतहों, उपकरणों और हाथों के ज़रिए फैल सकता है। अस्पतालों में खराब सफाई या हाइजीन से इसका संक्रमण तेजी से फैलता है।
कैसे बचाव करें?
-हाथों की नियमित सफाई करें।
-अस्पतालों में हाइजीन प्रोटोकॉल का सख्ती से पालन करें।
-जरूरत से ज्यादा एंटीबायोटिक दवाओं का उपयोग न करें।
-संक्रमित मरीजों को आइसोलेशन में रखा जाए।
-सरकारी और स्वास्थ्य एजेंसियों को सुपरबग की निगरानी बढ़ानी होगी।



